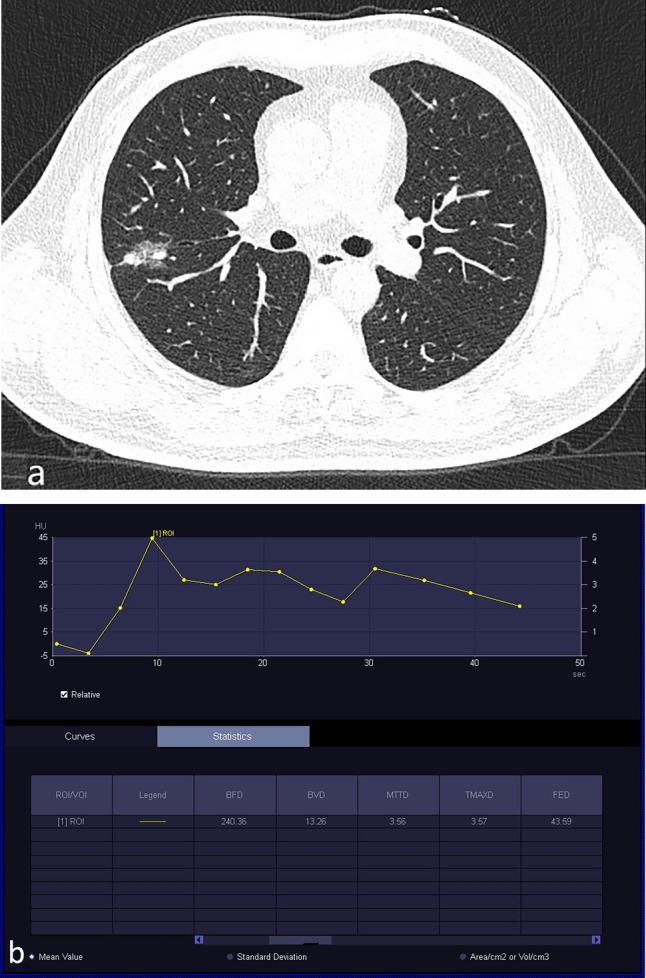
https://cdn.ncbi.nlm.nih.gov/pmc/blobs/ffaa/11269666/9ce23c72f630/41598_2024_68143_Fig4_HTML.jpg

低剂量双输入计算机断层灌注成像对肺良恶性磨玻璃结节鉴别诊断的诊断准确性。
Diagnostic accuracy of low-dose dual-input computed tomography perfusion in the differential diagnosis of pulmonary benign and malignant ground-glass nodules.
机构信息
Department of Radiology, Chengdu First People's Hospital, 18 Wanxiang North Road, Chengdu, 610000, Sichuan Province, China.
出版信息
Sci Rep. 2024 Jul 24;14(1):17098. doi: 10.1038/s41598-024-68143-x.
This study aimed to evaluate the value of low-dose dual-input computed tomography perfusion (CTP) imaging in the differential diagnosis of benign and malignant pulmonary ground-glass opacity nodules (GGO). A retrospective study was conducted in patients with GGO who underwent CTP in our hospital from January 2021 to October 2023. All nodules were confirmed via pathological analysis or disappeared during follow-up. Postprocessing analysis was conducted using the dual-input perfusion mode (pulmonary artery and bronchial artery) of the body perfusion software to measure the perfusion parameters of the pulmonary GGOs. A total of 101 patients with pulmonary GGOs were enrolled in this study, including 43 benign and 58 malignant nodules. The dose length product of the CTP (348 mGy.cm) was < 75% of the diagnostic reference level of the unenhanced chest CT (470 mGy.cm). The effective radiation dose was 4.872 mSV. The blood flow (BF), blood volume (BV), mean transit time (MTT), and flow extraction product (FEP) of malignant nodules were higher than those of the benign nodules (p < 0.05). The FEP had the highest accuracy for the diagnosis of malignant nodules (area under the curve [AUC] = 0.821, 95% confidence interval [CI]: 0.735-0.908) followed by BV (AUV = 0.713, 95% CI 0.608-0.819), BF (AUC = 0.688, 95% CI 0.587-0.797), and MTT (AUC = 0.616, 95% CI 0.506-0.726). When the FEP was ≥ 19.12 mL/100 mL/min, the sensitivity was 91.5% and the specificity was 62.8%. To distinguish between benign nodules and malignant nodules, the AUC of the combination of BV and FEP was 0.816 (95% CI 0.728-0.903), whereas the AUC of the combination of BF, BV, MTT, and FEP was 0.814 (95% CI 0.729-0.900). Low-dose dual-input perfusion CT was extremely effective in distinguishing between benign from malignant pulmonary GGOs, with FEP exhibiting the highest diagnostic capability.
本研究旨在评估低剂量双输入计算机断层灌注(CTP)成像在鉴别肺磨玻璃密度结节(GGO)良恶性中的价值。本回顾性研究纳入了 2021 年 1 月至 2023 年 10 月在我院行 CTP 的 GGO 患者。所有结节均经病理分析证实或随访中消失。采用体部灌注软件的双输入灌注模式(肺动脉和支气管动脉)对肺 GGO 的灌注参数进行后处理分析。本研究共纳入 101 例肺 GGO 患者,其中良性 43 例,恶性 58 例。CTP 的剂量长度乘积(348 mGy.cm)<未增强胸部 CT 诊断参考水平(470 mGy.cm)的 75%。有效辐射剂量为 4.872 mSV。恶性结节的血流量(BF)、血容量(BV)、平均通过时间(MTT)和血流提取产物(FEP)均高于良性结节(p<0.05)。FEP 对恶性结节的诊断具有最高的准确性(曲线下面积[AUC]为 0.821,95%置信区间[CI]:0.735-0.908),其次是 BV(AUC 为 0.713,95%CI 0.608-0.819)、BF(AUC 为 0.688,95%CI 0.587-0.797)和 MTT(AUC 为 0.616,95%CI 0.506-0.726)。当 FEP≥19.12 mL/100 mL/min 时,灵敏度为 91.5%,特异性为 62.8%。为鉴别良恶性结节,BV 和 FEP 联合的 AUC 为 0.816(95%CI 0.728-0.903),而 BF、BV、MTT 和 FEP 联合的 AUC 为 0.814(95%CI 0.729-0.900)。低剂量双输入灌注 CT 对鉴别肺 GGO 的良恶性非常有效,FEP 的诊断能力最高。